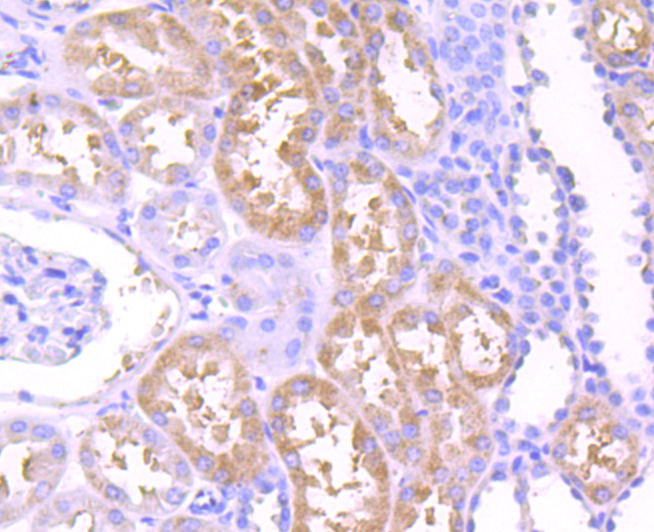
产品细节图片4

相关产品推荐更多 >
万千商家帮你免费找货
0 人在求购买到急需产品
- 详细信息
- 文献和实验
- 技术资料
- 免疫原:
Recombinant protein
- 形态:
liquid
- 保存条件:
Store at -20˚C
- 克隆性:
Polyclonal
- 适应物种:
Human;Mouse;Rat
- 保质期:
12 months
- 抗原来源:
Rabbit
- 供应商:
南京赛戈巍生物科技有限公司
- 宿主:
Rabbit
- 应用范围:
WB, ICC, IHC, FC
- 靶点:
Uniprot:Q08379
- 抗体英文名:
GM130 (cis-Golgi Marker) Antibody
- 规格:
50ul/100ul
130 kDa cis-Golgi matrix protein antibody
Cis golgi matrix protein GM130 antibody
GM130 antibody
Gm130 autoantigen antibody
GOGA2_HUMAN antibody
GOLGA 2 antibody
Golga2 antibody
Golgi autoantigen antibody
Golgi autoantigen golgin subfamily a 2 antibody
Golgi matrix protein GM130 antibody
Golgin 95 antibody
golgin A2 antibody
Golgin subfamily a 2 antibody
Golgin subfamily A member 2 antibody
Golgin-95 antibody
MGC20672 antibody
SY11 protein antibody
计算分子量:130 kDa
配方:1*TBS (pH7.4), 0.5%BSA, 50%Glycerol. Preservative: 0.05% Sodium Azide.
应用详情:WB: 1:500-1:2,000
IHC: 1:50-1:200
ICC: 1:50-1:200
FC: 1:50-1:200
图片:

Western blot analysis of GM130 on different cell lysate using anti-GM130 antibody at 1/1,000 dilution.
Positive control??
Lane1: MCF-7
Lane2: Hela
,

Immunohistochemical analysis of paraffin-embedded human tonsil tissue using anti-GM130 antibody. Counter stained with hematoxylin.
,

Immunohistochemical analysis of paraffin-embedded human liver tissue using anti-GM130 antibody. Counter stained with hematoxylin.
,
Immunohistochemical analysis of paraffin-embedded human kidney tissue using anti-GM130 antibody. Counter stained with hematoxylin.
,

Immunohistochemical analysis of paraffin-embedded mouse brain tissue using anti-GM130 antibody. Counter stained with hematoxylin.
,

ICC staining GM130 in LO2 cells (green). The nuclear counter stain is DAPI (blue). Cells were fixed in paraformaldehyde, permeabilised with 0.25% Triton X100/PBS.
,

Flow cytometric analysis of Hela cells with GM130 antibody at 1/100 dilution (red) compared with an unlabelled control (cells without incubation with primary antibody; black).
风险提示:丁香通仅作为第三方平台,为商家信息发布提供平台空间。用户咨询产品时请注意保护个人信息及财产安全,合理判断,谨慎选购商品,商家和用户对交易行为负责。对于医疗器械类产品,请先查证核实企业经营资质和医疗器械产品注册证情况。
文献和实验Reconstitution of Golgi Disassembly by Mitotic Xenopus Egg Extract in Semi-Intact MDCK Cells
apparatus was visualized in the cells by expression of green fluorescence protein (GFP)-tagged galactosyltransferase, a marker of trans-Golgi cisternae. Xenopus egg extracts arrested at mitosis or interphase were then prepared and added to the semi-intact
complexes formed by protein extracts prepared from different tissues can be compared to determine the tissue specificity of trans -acting factors. GMSA, coupled with specific antibody to trans -acting factor (antibody supershift assay), is used to identify
Expression of VHH Antibody Fragments in Saccharomyces cerevisiae
does not produce any toxins and is generally regarded as safe, simplifies the processes of downstream processing. Third, S. cerevisiae contains a secretion machinery comparable to the mammalian system, including an endoplasmic reticulum and Golgi. These organelles
技术资料暂无技术资料 索取技术资料






![ICAM1 Rabbit mAb[48883]](https://img1.dxycdn.com/p/s14/2025/0923/496/0462304380155040791.jpg!wh200)
![TGIF1 Rabbit Polyclonal Antibody[54339]](https://img1.dxycdn.com/p/s14/2025/0922/498/0460884283108299691.jpg!wh200)
![cPLA2 Polyclonal Conjugated Antibody[C41585]](https://img1.dxycdn.com/p/s14/2025/0923/278/4431488150116040791.jpg!wh200)
